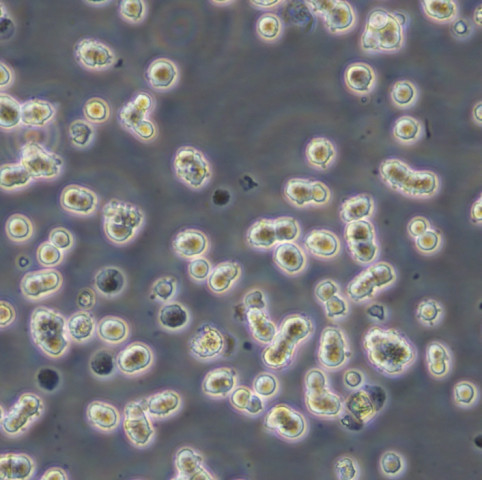
CT26WT Cells小鼠结肠癌贴壁细胞系(提供全部细胞STR鉴定图谱)

"CT26WT Cells小鼠结肠癌贴壁细胞系(提供全部细胞STR鉴定图谱)
传代比例:1:2-1:4(首次传代建议1:2)
背景信息:CT26细胞是被N-亚硝基-N-甲基脲烷(NNMU)诱导得到的未分化的小鼠结肠癌细胞,该细胞的一个克隆形成的细胞系被命名为CT26.WT。CT26.WT被逆转录病毒载体LXSN稳定转化形成了一个致死性的亚克隆CT26.CL25,这一病毒载体含有lacZ基因、编码肿瘤相关抗原(TAA)和beta半乳糖苷酶。CT26.WT和CT26.CL25细胞在小鼠中生长速度和致死率都很相似,不同的是CT26.CL25细胞可以表达肿瘤相关抗原和beta半乳糖苷酶,因此这两株细胞可以联合用于免疫治疗和宿主免疫反应的研究。
┈订┈购(技术服务)┈热┈线:1┈3┈6┈4┈1┈9┈3┈0┈7┈9┈1【微信同号】┈Q┈Q:3┈1┈8┈0┈8┈0┈7┈3┈2┈4;
HCC1395 Cells;背景说明:详见相关文献介绍;传代方法:1:2传代,每周换液2—3次;生长特性:贴壁生长;形态特性:上皮样;相关产品有:COLO-829细胞、3T6细胞、Human Fetal Thymocyte-8810细胞
CAL39 Cells;背景说明:外阴鳞癌细胞;女性;传代方法:1:2-1:3传代;每周换液2-3次。;生长特性:贴壁;形态特性:详见产品说明书;相关产品有:SK-UT-1细胞、RBE细胞、BT-20细胞
H-2052 Cells;背景说明:详见相关文献介绍;传代方法:1:3-1:6传代;生长特性:贴壁生长;形态特性:上皮细胞;相关产品有:SUM149-PT细胞、SCL II细胞、Hs 863.T细胞
UMC-11 Cells;背景说明:肺肿瘤;男性;传代方法:1:2-1:3传代;每周换液2-3次。;生长特性:贴壁;形态特性:详见产品说明书;相关产品有:Human Embryo Kidney-2细胞、TSCCa细胞、SNU-620细胞
换液周期:每周2-3次
为什么培养的细胞要及时传代?体外培养的细胞大多具有生长接触抑制的性,也就是说当一个细胞被其他细胞包围的时候,它就会停止生长,及时传代后,细胞的生长得以继续。培养细胞生长减慢的原因在哪些?其解决办法有哪些?可能的原因有:更换了不同的培养或血清;培养中一些细胞生长必需成分如谷眈肢或生长因子等耗尽或缺乏或己被破坏;培养物中有少量细菌或真菌污染;试剂保存不当;比较新培养与原培养成分,比较新血清与旧血清等,找出其它可能的原因。解决办法:增加起始培养细胞浓度;让细胞逐渐适应新培养;换入新鲜配制培养;补加谷酷肢或生长因子等;用无抗生素培养培养,如发现污染,去弃培养物,或用抗生素除菌;血清需保存在5℃到20℃; 培养需在2-8℃避光保存;含血清完全培养在2-8℃保存,并在2周内用完;分离培养物,检测支原体。冷冻管应如何解冻?取出冷冻管后,须立即放入37℃水槽中快速解冻,轻摇冷冻管使其在1-2分钟内大部分融化,别注意,需残留一小块冰块,就可拿到超净工作台操作细胞,用75%酒精消毒冻存管,用新鲜培养基将细胞转移至培养瓶。另外冷冻管由桶中取出解冻时,必须注意安全,预防冷冻管爆裂。
CT26WT Cells小鼠结肠癌贴壁细胞系(提供全部细胞STR鉴定图谱)
生长特性:贴壁生长
产品包装:复苏发货:T25培养瓶(一瓶)或冻存发货:1ml冻存管(两支)
PANC0403 Cells;背景说明:详见相关文献介绍;传代方法:1:2传代;生长特性:贴壁生长;形态特性:上皮样;相关产品有:L-540细胞、RGE细胞、A704细胞
Line 207 Cells;背景说明:儿童急性髓系白血病;传代方法:1:2-1:3传代;每周换液2-3次。;生长特性:悬浮;形态特性:详见产品说明书;相关产品有:HCC1806细胞、BC-022细胞、U251-MG细胞
QGY-7703 Cells;背景说明:该细胞系来自35岁女性的肝癌。染色体数目变化大,异倍体多。免疫荧光间接法AFP阳性反应。异体移植能力强。亚显微结构方面,核与细胞质的比例高,大的多形核和多种细胞器亚显微结构改变。在ConA作用下凝集。倍增时间约为20.5小时。用Northernblot方法,未能检测到细胞中1.3kbLFIRE-1/HFREP-1mRNA的表达。;传代方法:消化3-5分钟,1:2,3天内可长满;生长特性:贴壁生长;形态特性:上皮样;相关产品有:FLC7细胞、PFSK1细胞、MDCK2细胞
JB6 Cl 30-7b Cells;背景说明:详见相关文献介绍;传代方法:1:2传代;生长特性:贴壁生长;形态特性:上皮样;相关产品有:T-ALL-1细胞、Jurkat-77细胞、NCI-H2030细胞
┈订┈购(技术服务)┈热┈线:1┈3┈6┈4┈1┈9┈3┈0┈7┈9┈1【微信同号】┈Q┈Q:3┈1┈8┈0┈8┈0┈7┈3┈2┈4;
来源说明:细胞主要来源ATCC、ECACC、DSMZ、RIKEN等细胞库
细胞接收操作说明:请仔细阅读本操作说明及相应的细胞说明书。本公司细胞发货有四种形式:25培养瓶(一般是贴壁细胞使用,悬浮细胞也可以)、离心管(悬浮细胞使用多,当然,有些公司也会用这种离心管形式发贴壁细胞,但是,长期经验来说,贴壁细胞容易发生形态变化,估计是细胞培养空间狭小,血清不足导致(Zui主要是怕运输延误导致这些情况发生),个人不建议用离心管形式发贴壁细胞)及干冰(冻存细胞用,主要是冬天天气冷,温度低于4℃的地方,都要考虑冻存细胞)。25培养瓶:是用25细胞培养瓶直接发货的形式。收到细胞后,拆开包装25培养瓶的自封袋,不拆封口膜,表面喷75%酒精消毒后显微镜观察细胞状态(有条件可以拍下此时细胞照片)。将细胞放入37度培养箱平衡两小时以上,再处理细胞。首先将25中培养基取出装HAO备用,如细胞密度GAO于80%,可以直接消化传代,相反则加入5-6ml培养基放回培养箱继续培养即可。离心管:是用15ml离心管发货的形式,只用于悬浮细胞发货。收到细胞后消毒处理及将细胞放入37度培养箱平衡两小时以上,再处理细胞。首先将25中培养基取出装HAO备用(如果实验室没有25培养瓶,可以暂时75培养瓶,加入10-15ml培养基,建议10ml培养基,也可以使用175培养瓶,加入50-60ml培养基,培养瓶越大,需要的培养基越多。当然如果刚接收到细胞密度不够的话,ZuiHAO不用大瓶子,先用小瓶子养起来再换大的,不然会长得很慢,严重的,会导致细胞死亡等危险),平衡完成后,离心(1000rpm,3min)收集细胞,弃上清,用新的培养基重悬细胞并接种至培养瓶或皿中,放回培养箱继续培养。干冰:是用本公司冻存冻存细胞后,直接用干冰将冻存的细胞冷冻发货的形式。收到细胞后按照细胞复苏的步骤操作即可。
物种来源:人源、鼠源等其它物种来源
CT26WT Cells小鼠结肠癌贴壁细胞系(提供全部细胞STR鉴定图谱)
形态特性:成纤维细胞
上皮细胞(epithelial cell)是构成上皮组织的基本单位,广泛分布在人体的各个表面和体腔内,外胚层来源:皮肤、腺垂体、内耳膜、角膜、晶状体、鼻腔、口腔、肛门等处的上皮细胞由外胚层发育而来。中胚层来源:间皮、内皮等上皮细胞由中胚层发育而来。内胚层来源:中耳、呼吸道、肺、胸腺、消化道、消化腺、膀胱、阴道、甲状腺、甲状旁腺等处的上皮细胞由内胚层发育而来。许多癌症起源于上皮细胞,如肝细胞癌、结直肠癌、乳腺癌、肺癌、胃癌、前列腺癌、卵巢癌和子宫内膜癌。这些癌症中的上皮细胞通常表现出细胞标志物的变化,如E-cadherin的缺失和N-cadherin、vimentin等间充质细胞标志物的表达上调。
Abcam A-549 DTX3L KO 1 Cells(提供STR鉴定图谱)
Abcam THP-1 EPHB4 KO Cells(提供STR鉴定图谱)
BayGenomics ES cell line CSC063 Cells(提供STR鉴定图谱)
BayGenomics ES cell line RRS576 Cells(提供STR鉴定图谱)
BayGenomics ES cell line YTC041 Cells(提供STR鉴定图谱)
chHES-38 Cells(提供STR鉴定图谱)
DA02034 Cells(提供STR鉴定图谱)
Dopa.4U Cells(提供STR鉴定图谱)
GM03440 Cells(提供STR鉴定图谱)
UPCI:SCC154 Cells;背景说明:舌鳞癌;男性;HPV6转化;传代方法:1:2-1:3传代;每周换液2-3次。;生长特性:贴壁;形态特性:详见产品说明书;相关产品有:PTK1细胞、Lu99A细胞、HSC3细胞
HSC-6 Cells;背景说明:口腔鳞癌;传代方法:1:2-1:3传代;每周换液2-3次。;生长特性:贴壁;形态特性:详见产品说明书;相关产品有:PC3M-2B4细胞、OVCAR.8细胞、Ca Ski细胞
D6P2T Cells;背景说明:详见相关文献介绍;传代方法:1:5—1:10传代;生长特性:贴壁生长;形态特性:神经元 ;相关产品有:HFL1细胞、SAS细胞、Hs 675.T细胞
Caco-2BBe Cells;背景说明:详见相关文献介绍;传代方法:1:6—1:10传代,每周换液2次;生长特性:贴壁生长;形态特性:上皮细胞;相关产品有:SW 954细胞、SCC-9细胞、NCI-H2141细胞
Rin-M-5F Cells;背景说明:胰岛β细胞瘤;雄性;NEDH;传代方法:1:2-1:3传代;每周换液2-3次。;生长特性:贴壁;形态特性:详见产品说明书;相关产品有:HuP-T3细胞、HCC-1806细胞、EOC-20细胞
QGY 7701 Cells;背景说明:详见相关文献介绍;传代方法:消化3-5分钟,1:2,3天内可长满;生长特性:贴壁生长;形态特性:上皮样;相关产品有:NCI H23细胞、HOPC细胞、MS1细胞
MLMA Cells;背景说明:详见相关文献介绍;传代方法:1:2传代;生长特性:悬浮生长;形态特性:淋巴母细胞;相关产品有:NCI-H727细胞、COLO-16细胞、SW1417细胞
TCCSUP Cells;背景说明:详见相关文献介绍;传代方法:1:2-1:3传代,2-3天换液1次。;生长特性:贴壁生长;形态特性:上皮细胞;相关产品有:DiFi细胞、FOX-NY细胞、KYSE-70细胞
C-8161 Cells;背景说明:皮肤黑色素瘤;腹壁转移;女性;传代方法:1:2-1:3传代;每周换液2-3次。;生长特性:贴壁;形态特性:详见产品说明书;相关产品有:PLB-985细胞、BS-C-1细胞、SNU-423细胞
RT 112 Cells;背景说明:详见相关文献介绍;传代方法:1:2-1:3传代;每周换液2-3次。;生长特性:贴壁或悬浮,详见产品说明书部分;形态特性:详见产品说明书;相关产品有:PLC/PRF5细胞、H-2291细胞、KYSE0520细胞
MGC-803 Cells;背景说明:1980年建系,人胃癌低分化黏液腺癌组织小块用RPMI-1640培养液培养4天细胞开始生长,首次传代8日。免疫抑制的Wistar雄幼大鼠皮下移植成功。;传代方法:1:3传代,2-3天换液一次;生长特性:贴壁生长;形态特性:上皮样;相关产品有:NMC-G1细胞、Leukemic 1210细胞、SKMEL-24细胞
DHL-2 Cells;背景说明:弥漫性大细胞淋巴瘤;胸腔积液转移;女性;传代方法:1:2-1:3传代;每周换液2-3次。;生长特性:悬浮;形态特性:详见产品说明书;相关产品有:Normal Rat Kidney细胞、PL11细胞、Fu97细胞
KS-SLK Cells;背景说明:肉瘤;传代方法:1:2-1:3传代;每周换液2-3次。;生长特性:贴壁;形态特性:详见产品说明书;相关产品有:SNU-668细胞、Mink Lung细胞、Nthy-ori 3-1细胞
OVCAR-433 Cells;背景说明:卵巢癌;女性;传代方法:1:2-1:3传代;每周换液2-3次。;生长特性:贴壁;形态特性:详见产品说明书;相关产品有:MDA-MB-435 S细胞、BC3H1细胞、Hs578Bst细胞
MC-26 Cells;背景说明:详见相关文献介绍;传代方法:1:2-1:3传代;每周换液2-3次。;生长特性:贴壁或悬浮,详见产品说明书部分;形态特性:详见产品说明书;相关产品有:HCC-1428细胞、C3A细胞、Hs 683细胞
QGP-1 Cells;背景说明:胰腺癌;男性;传代方法:1:2-1:3传代;每周换液2-3次。;生长特性:贴壁;形态特性:详见产品说明书;相关产品有:BALB 3T3 clone A31细胞、HSC-1细胞、JB6 Cl 30细胞
QGP-1 Cells;背景说明:胰腺癌;男性;传代方法:1:2-1:3传代;每周换液2-3次。;生长特性:贴壁;形态特性:详见产品说明书;相关产品有:BALB 3T3 clone A31细胞、HSC-1细胞、JB6 Cl 30细胞
CT26WT Cells小鼠结肠癌贴壁细胞系(提供全部细胞STR鉴定图谱)
GM02219 Cells;背景说明:MOLT-4与MOLT-3来源于一名19岁的男性急性淋巴细胞性白血病的复发患者,该患者前期接受过多种药物联合化疗。MOLT-4细胞系为T淋巴细胞起源,p53基因的第248位密码子有一个G→A突变,不表达p53,不表达免疫球蛋白或EB病毒;可产生高水平的末端脱氧核糖转移酶;表达CD1(49%),CD2(35%),CD3A(26%)B(33%)C(34%),CD4(55%),CD5(72%),CD6(22%),CD7(77%)。;传代方法:1:2传代;生长特性:悬浮生长;形态特性:淋巴母细胞样;圆形;相关产品有:KMY1022细胞、KP-2细胞、MDA 231-LM2-4175细胞
SNU-638 Cells;背景说明:详见相关文献介绍;传代方法:1:2-1:3传代;每周换液2-3次。;生长特性:贴壁或悬浮,详见产品说明书部分;形态特性:详见产品说明书;相关产品有:Hu-P-T4细胞、VeroC1008细胞、Anip[973]细胞
TE85 Cells;背景说明:骨肉瘤;女性;传代方法:1:2-1:3传代;每周换液2-3次。;生长特性:贴壁;形态特性:详见产品说明书;相关产品有:tdott细胞、NCIH208细胞、Hs 840.T细胞
COLO684 Cells;背景说明:详见相关文献介绍;传代方法:1:2传代;生长特性:悬浮生长;形态特性:详见产品说明书;相关产品有:GP5d细胞、MDA134细胞、SNUC1细胞
RCF Cells;背景说明:心肌;成纤维 Cells;传代方法:1:2-1:3传代;每周换液2-3次。;生长特性:贴壁;形态特性:详见产品说明书;相关产品有:HA细胞、Malme-3 M细胞、MRASMC细胞
HNEpC Cells;背景说明:鼻粘膜;上皮 Cells;传代方法:1:2-1:3传代;每周换液2-3次。;生长特性:贴壁;形态特性:详见产品说明书;相关产品有:Jurkat-77细胞、M-NFS-60细胞、C4-I细胞
┈订┈购(技术服务)┈热┈线:1┈3┈6┈4┈1┈9┈3┈0┈7┈9┈1【微信同号】┈Q┈Q:3┈1┈8┈0┈8┈0┈7┈3┈2┈4;
Hs852T Cells;背景说明:详见相关文献介绍;传代方法:1:2-1:3传代;每周换液2-3次。;生长特性:贴壁生长;形态特性:上皮细胞;相关产品有:UCLA NPA871细胞、NCI-H1573细胞、KTA-7细胞
MDA-MB-175VII Cells;背景说明:该细胞源自一位54岁患有乳腺导管癌白人女性的胸腔积液。;传代方法:1:2—1:6传代,每周换液2—3次;生长特性:松散贴壁生长;形态特性:上皮细胞样;相关产品有:H-2108细胞、SF767细胞、BNL-HCC细胞
TK.10 Cells;背景说明:详见相关文献介绍;传代方法:1:3-1:6传代;2-3天换液1次。;生长特性:贴壁生长;形态特性:上皮样;相关产品有:HeLa/DDP细胞、ECV-304细胞、TOV112细胞
PANC 327 Cells;背景说明:详见相关文献介绍;传代方法:1:2传代;生长特性:贴壁生长;形态特性:上皮样;相关产品有:HepG2/C3A细胞、PC-3M IE8细胞、2E8细胞
HIMEC Cells;背景说明:肠微血管内皮 Cells;传代方法:1:2-1:3传代;每周换液2-3次。;生长特性:贴壁;形态特性:详见产品说明书;相关产品有:NCI-157细胞、2V6.11细胞、SCL-2细胞
TE8 Cells;背景说明:详见相关文献介绍;传代方法:消化3-5分钟。1:2。3天内可长满。;生长特性:贴壁生长;形态特性:上皮样;相关产品有:RASMC细胞、NKM-1细胞、PLA-801D细胞
GM22185 Cells(提供STR鉴定图谱)
HAP1 MERTK (-) 1 Cells(提供STR鉴定图谱)
HEC-1-A-OZA3 Cells(提供STR鉴定图谱)
HPSI0816i-oemk_6 Cells(提供STR鉴定图谱)
KBM-7/B5-1803 Cells(提供STR鉴定图谱)
MF15 Cells(提供STR鉴定图谱)
NIH 3T3/HER2-3(400) Cells(提供STR鉴定图谱)
RARE Cells(提供STR鉴定图谱)
STAN053i-149-1 Cells(提供STR鉴定图谱)
Ubigene HEK293 CNTFR KO Cells(提供STR鉴定图谱)
WFS2_1#24 Cells(提供STR鉴定图谱)
6.2B10 Cells(提供STR鉴定图谱)
Tu 212 Cells;背景说明:详见相关文献介绍;传代方法:1:2传代;生长特性:贴壁生长 ;形态特性:详见产品说明书;相关产品有:H-187细胞、769P细胞、ssMCF7细胞
KP4 Cells;背景说明:详见相关文献介绍;传代方法:1:2-1:3传代;每周换液2-3次。;生长特性:贴壁生长;形态特性:详见产品说明书;相关产品有:NS653细胞、F9细胞、VP229细胞
H2052_MM Cells;背景说明:详见相关文献介绍;传代方法:1:3-1:6传代;生长特性:贴壁生长;形态特性:上皮细胞;相关产品有:SNU-368细胞、GBCSD细胞、WM 451-Lu细胞
G 292 Clone A 141B1 Cells;背景说明:详见相关文献介绍;传代方法:1:2-1:3传代;每周换液2-3次。;生长特性:贴壁或悬浮,详见产品说明书部分;形态特性:详见产品说明书;相关产品有:T-HEECs细胞、COV504细胞、X63-AG 8.653细胞
RS4:11 Cells;背景说明:详见相关文献介绍;传代方法:每周2-3次;生长特性:悬浮生长;形态特性:成淋巴细胞;相关产品有:PC-3/M细胞、Ramos (RA 1)细胞、COLO-394细胞
Highly Aggressively Proliferating Immortalized Cells;背景说明:小胶质细胞;自发永生;Wistar;传代方法:1:2-1:3传代;每周换液2-3次。;生长特性:半贴壁;形态特性:详见产品说明书;相关产品有:THP 1细胞、IGR-OV1细胞、BHK-21细胞
MNNG-HOS Cells;背景说明:骨肉瘤;女性;传代方法:1:2-1:3传代;每周换液2-3次。;生长特性:贴壁;形态特性:详见产品说明书;相关产品有:OCI-LY-3细胞、GB1细胞、TMD-8细胞
B-3 Cells;背景说明:晶状体;Ad12-SV40转化;男性;传代方法:1:2-1:3传代;每周换液2-3次。;生长特性:贴壁;形态特性:详见产品说明书;相关产品有:COLO-738细胞、Hs578Bst细胞、H-2452细胞
CCK81 Cells;背景说明:详见相关文献介绍;传代方法:1:2-1:3传代;每周换液2-3次。;生长特性:贴壁或悬浮,详见产品说明书部分;形态特性:详见产品说明书;相关产品有:HLE-B3细胞、IOSE29细胞、NCI H23细胞
SUM 159PT Cells;背景说明:乳腺癌;女性;传代方法:1:2-1:3传代;每周换液2-3次。;生长特性:贴壁;形态特性:详见产品说明书;相关产品有:GM02132细胞、TE-5细胞、P3-X63Ag8.653细胞
Sp2/0-Ag14 Cells;背景说明:该细胞是由绵羊红细胞免疫的BALB/c小鼠脾细胞和P3X63Ag8骨髓瘤细胞融合得到的。该细胞不分泌免疫球蛋白,对20μg/ml的8-氮鸟嘌呤有抗性,对HAT比较敏感;该细胞可以作为细胞融合时的B细胞组分用于制备杂交瘤;鼠痘病毒阴性。;传代方法:1:2传代;生长特性:悬浮生长;形态特性:淋巴母细胞样;圆形;相关产品有:SUDHL5细胞、OCI-Ly 8细胞、CEMO-1细胞
SNU354 Cells;背景说明:详见相关文献介绍;传代方法:1:2传代;生长特性:贴壁生长;形态特性:上皮细胞样;相关产品有:NCI522细胞、PK (15)细胞、BN-CL2细胞
HEK;293 Cells;背景说明:详见相关文献介绍;传代方法:1:2-1:3传代;每周换液2-3次。;生长特性:贴壁或悬浮,详见产品说明书部分;形态特性:详见产品说明书;相关产品有:HCC1954 BL细胞、B16/F1细胞、PaTu 8988 S细胞
HT-1080 Cells;背景说明:该细胞源自一名35岁患有纤维肉瘤的白人男性的结缔组织;ras+。;传代方法:1:4-1:8传代;2-3天换液1次。;生长特性:贴壁生长;形态特性:上皮样;相关产品有:AMJ2C8细胞、Capan-2细胞、U266细胞
OEC33 Cells;背景说明:详见相关文献介绍;传代方法:1:2传代;生长特性:贴壁生长;形态特性:上皮样;相关产品有:ZR-75-1细胞、HPF细胞、Wien133细胞
Strain V Cells;背景说明:肺;自发永生;雄性;传代方法:1:2-1:3传代;每周换液2-3次。;生长特性:贴壁;形态特性:详见产品说明书;相关产品有:NeHepLxHT细胞、Stanford University-Diffuse Histiocytic Lymphoma-4细胞、SUDHL6细胞
THP-1 Cells;背景说明:该细胞从一名1岁的患有急性单核细胞性白血病的男孩的外周血中分离建立。该细胞可以吞噬乳胶颗粒和激活的红细胞,细胞膜和胞浆内均没有免疫球蛋白,表达C3R和FcR;可受佛波酯TPA诱导向单核系方向分化;可作为转染宿主。;传代方法:维持细胞浓度在2-4×105-8×105/ml,勿超过1×106/ml;2-3天换液1次。;生长特性:悬浮生长;形态特性:单核细胞;相关产品有:OVCAR420细胞、P388-D1细胞、High Five细胞
G 292 Clone A 141B1 Cells;背景说明:详见相关文献介绍;传代方法:1:2-1:3传代;每周换液2-3次。;生长特性:贴壁或悬浮,详见产品说明书部分;形态特性:详见产品说明书;相关产品有:T-HEECs细胞、COV504细胞、X63-AG 8.653细胞
H-2126 Cells;背景说明:详见相关文献介绍;传代方法:1:2-1:4传代,每周2-3次。;生长特性:贴壁生长;形态特性:上皮细胞样;相关产品有:A253细胞、VCaP细胞、Be Wo细胞
ANA1 Cells;背景说明:详见相关文献介绍;传代方法:1:2传代;生长特性:悬浮生长;形态特性:详见产品说明书;相关产品有:C-127细胞、KBM7细胞、H-2081细胞
High5 Cells;背景说明:详见相关文献介绍;传代方法:1:2-1:3传代;每周换液2-3次。;生长特性:贴壁或悬浮,详见产品说明书部分;形态特性:详见产品说明书;相关产品有:C2BBe 1细胞、Kit225 K6细胞、BrCL15细胞
H-295 Cells;背景说明:详见相关文献介绍;传代方法:1:2-1:3传代;每周换液2-3次。;生长特性:贴壁或悬浮,详见产品说明书部分;形态特性:详见产品说明书;相关产品有:RDES-1细胞、LOU-NH91细胞、T-cell Acute Lymphoblastic Leukemia-1细胞
A2058 Cells;背景说明:详见相关文献介绍;传代方法:1:6-1:12传代,2-3天换液1次。;生长特性:贴壁生长;形态特性:上皮细胞;相关产品有:SW-480细胞、AMC-HN8细胞、A7r5细胞
P30/0HK Cells;背景说明:详见相关文献介绍;传代方法:10^5 cells/60mm dish;生长特性:悬浮生长;形态特性:淋巴母细胞;相关产品有:UMUC3细胞、H2107细胞、293 Ad5细胞
H7721 Cells;背景说明:用Northernblot方法,未能检测到细胞中1.3kbLFIRE-1/HFREP-1mRNA的表达。;传代方法:1:3传代,2-3天换液一次;生长特性:贴壁生长;形态特性:上皮样;相关产品有:OCI-Ly 18细胞、NCIH2073细胞、PY8119细胞
CAL 62 Cells;背景说明:详见相关文献介绍;传代方法:1:2-1:3传代;每周换液2-3次。;生长特性:贴壁或悬浮,详见产品说明书部分;形态特性:详见产品说明书;相关产品有:NTC200细胞、TB1 Lu细胞、SP2-0-Ag14细胞
A3 Cells;背景说明:详见相关文献介绍;传代方法:1:2-1:3传代;每周换液2-3次。;生长特性:贴壁或悬浮,详见产品说明书部分;形态特性:详见产品说明书;相关产品有:SF-763细胞、X63-Ag8-653细胞、NPA87细胞
CT26WT Cells小鼠结肠癌贴壁细胞系(提供全部细胞STR鉴定图谱)
H-841 Cells;背景说明:详见相关文献介绍;传代方法:1:3—1:5传代,;生长特性:混合型生长;形态特性:详见产品说明书;相关产品有:SUM 102PT细胞、MES-SA细胞、CEM/0细胞
MSTO211H Cells;背景说明:MSTO-211H细胞株是1985年从一位肺二相间皮瘤患者的胸水中建株的。这个病人接受过多种药物联合前期化疗。MSTO-211H细胞具有高亲和力的EGF结合位点,并表达神经元特异性烯醇酶(NSE)及人绒毛膜促性腺激素(HCG)的α与β亚基。未检测到左旋多巴胺脱羧酶(DDC),邦巴辛与神经tensin。细胞过表达c-myc原癌基因,并没有观察到基因重排或扩增。V-src,v-abl,v-erbB,c-raf1,Ha-ras,Ki-ras,和N-ras的表达呈阳性。未检测到N-m;传代方法:消化3-5分钟。1:2。3天内可长满。;生长特性:贴壁生长;形态特性:成纤维细胞样;相关产品有:NFS-60细胞、SUM-159PT细胞、CATH-a细胞
SCC 9 Cells;背景说明:详见相关文献介绍;传代方法:1:2传代;生长特性:贴壁生长;形态特性:上皮样;相关产品有:MLE-12细胞、SK-MEL-24细胞、GM03671C细胞
MV-4-11 Cells;背景说明:详见相关文献介绍;传代方法:1:2-1:3传代;每周换液2-3次。;生长特性:贴壁或悬浮,详见产品说明书部分;形态特性:详见产品说明书;相关产品有:OCILY-3细胞、SPC-A1细胞、UACC-893细胞
C-28I2 Cells;背景说明:软骨;SV40转化;女性;传代方法:1:2-1:3传代;每周换液2-3次。;生长特性:贴壁;形态特性:详见产品说明书;相关产品有:RPPVEC细胞、H-1650细胞、NCI-H1993细胞
OCI-Ly 18 Cells;背景说明:弥漫大B细胞淋巴瘤;男性;传代方法:1:2-1:3传代;每周换液2-3次。;生长特性:悬浮;形态特性:详见产品说明书;相关产品有:8305C细胞、F81细胞、P-3J细胞
TALL1 Cells;背景说明:该细胞源于一名复发T-ALL(急性T淋巴细胞性白血病)的儿童的外周血;具有很强的细胞毒性,体内体外实验中都能破坏肿瘤细胞;IL-2可使细胞更好地生长;α/β TCR阳性,γ/δ TCR阴性;可产生IFNγ、TNF-α和GM-CSF。;传代方法:维持细胞密度在4×105-1×106 cells/ml之间,2-3天换液1次 ;生长特性:悬浮生长;形态特性:淋巴母细胞;相关产品有:VERO76细胞、3T3-L1 ad细胞、HBVP细胞
OCI-Ly8 Cells;背景说明:弥漫大B淋巴瘤;传代方法:1:2-1:3传代;每周换液2-3次。;生长特性:悬浮;形态特性:详见产品说明书;相关产品有:FRTL5细胞、LS 180细胞、BCaP-37细胞
┈订┈购(技术服务)┈热┈线:1┈3┈6┈4┈1┈9┈3┈0┈7┈9┈1【微信同号】┈Q┈Q:3┈1┈8┈0┈8┈0┈7┈3┈2┈4;
SKNBE(2) Cells;背景说明:1972年11月从一们多次化疗及放疗的扩散性神经母细胞瘤患儿骨髓穿刺物中建立了SK-N-BE(2)神经母细胞瘤细胞株。 该细胞显示中等水平的多巴胺-β-羟基酶活性。 有报道称SK-N-BE(2)细胞的饱和浓度超过1x106细胞/平方厘米。细胞形态多样,有的有长突触,有的呈上皮细胞样。 细胞会聚集,形成团块并浮起;传代方法:1:2传代;生长特性:贴壁生长;形态特性:上皮细胞样;相关产品有:786-0WT细胞、AGS细胞、Vero 76 clone E6细胞
SUD-4 Cells;背景说明:详见相关文献介绍;传代方法:1:2-1:3传代;每周换液2-3次。;生长特性:悬浮;形态特性:淋巴母细胞;相关产品有:OC-316细胞、C 6细胞、L6565细胞
Rh30 Cells;背景说明:肺泡横纹肌肉瘤;骨髓转移;传代方法:1:2-1:3传代;每周换液2-3次。;生长特性:贴壁;形态特性:详见产品说明书;相关产品有:PLA801C细胞、GM03570E细胞、SK UT 1细胞
BayGenomics ES cell line RRF094 Cells(提供STR鉴定图谱)
BayGenomics ES cell line XG273 Cells(提供STR鉴定图谱)
EA5.12 Cells(提供STR鉴定图谱)
MOR115.1.13 Cells(提供STR鉴定图谱)
TIMI.4 Cells(提供STR鉴定图谱)
M14-CDM Cells(提供STR鉴定图谱)
"